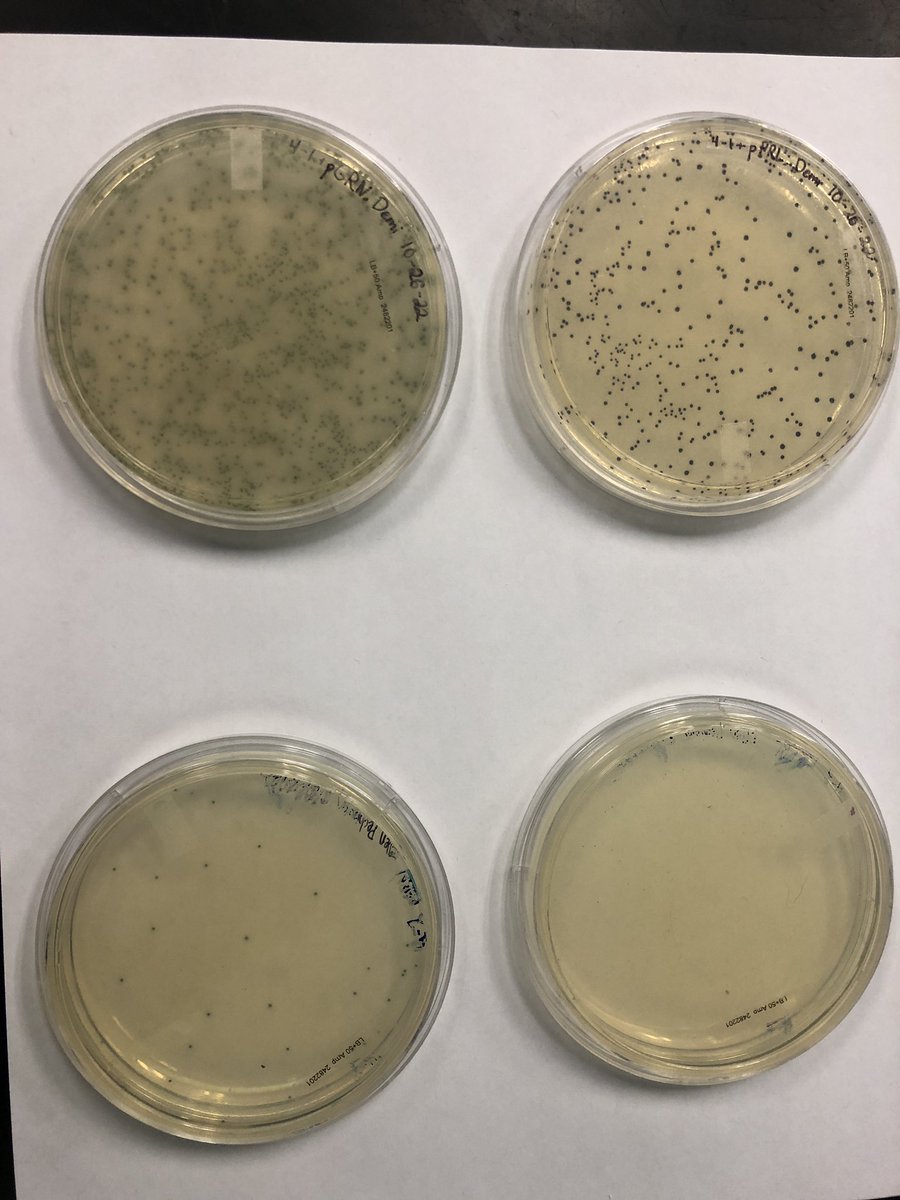
Lindsey LEcuyer tweet media

Sabitlenmiş Tweet

What a morning celebrating the #BioBuilderClub work of Puloma and Veni!!!! @SystemsSally @Andover_HS boston25news.com/news/andover-s…




English
Lindsey LEcuyer
534 posts

@AHSbiotech
Grower of fellow biology enthusiasts at Andover High School. Runner. Zoe's mom.